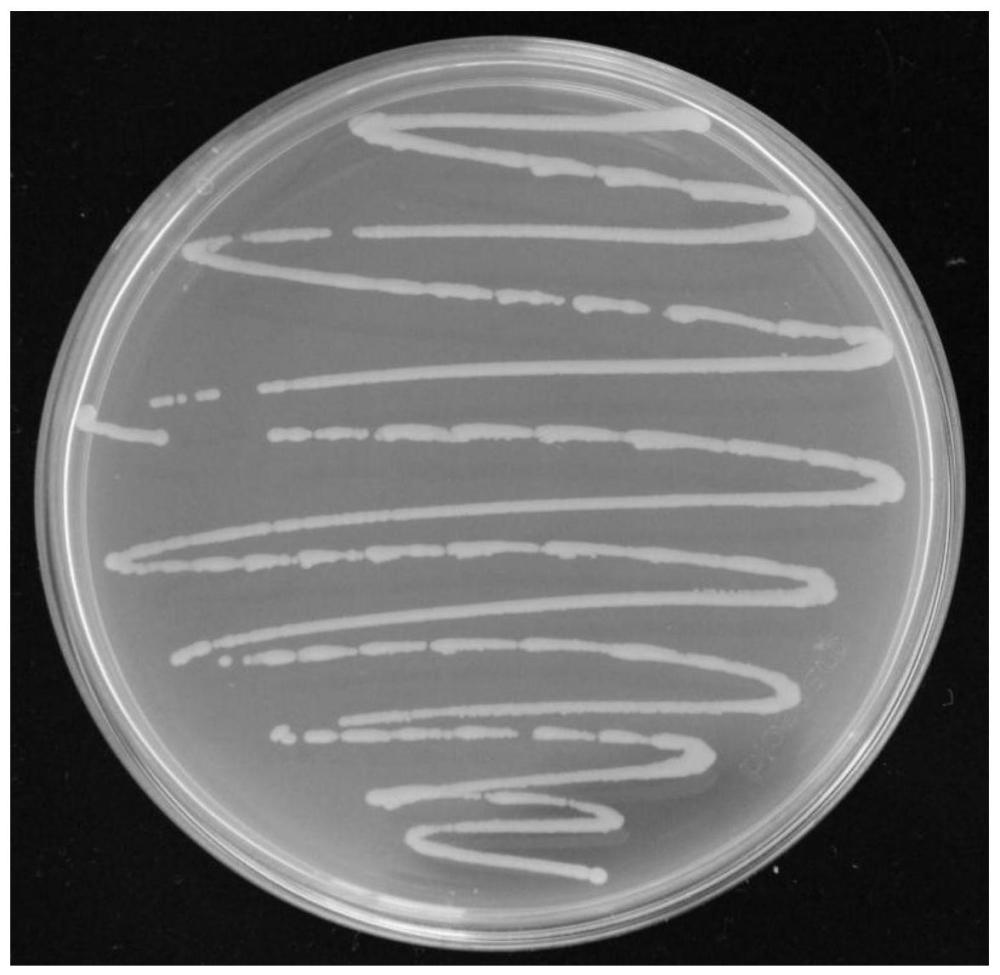
一株可分泌IAA的耐鹽堿促生菌YS-AT1及其應(yīng)用

生物醫(yī)藥
一株可分泌IAA的耐鹽堿促生菌YS-AT1及其應(yīng)用
本發(fā)明公開本發(fā)明公開了一株具備分泌IAA能力的耐鹽堿菌及其應(yīng)用���,該菌隸屬于Klebslella屬����,已于2021年3月23日保藏于中國典型培養(yǎng)物保藏中心����,保藏編號(hào)M2021237。該菌株具有較強(qiáng)的耐鹽和耐堿特性����,其生長耐受的NaCl濃度>9%(w/v)����,能耐受的pH值為8.0~12.0���,且在不同pH生長條件下均具有一定的降堿能力,不同pH生長條件下降堿范圍為2.7%~13.8%����。同時(shí),該菌在L?色氨酸誘導(dǎo)下分泌IAA能力可達(dá)到5.38μg·mL?1���。此外����,該菌對(duì)小麥種子萌發(fā)和鹽堿條件下擬南芥幼苗生長具有明顯的促進(jìn)作用����。因此,該菌將在制備用于鹽堿地區(qū)的促生微生物菌劑等方面具有重要的應(yīng)用價(jià)值���。
中國科學(xué)院東北地理與農(nóng)業(yè)生態(tài)研究所農(nóng)業(yè)技術(shù)中心
授權(quán)發(fā)明